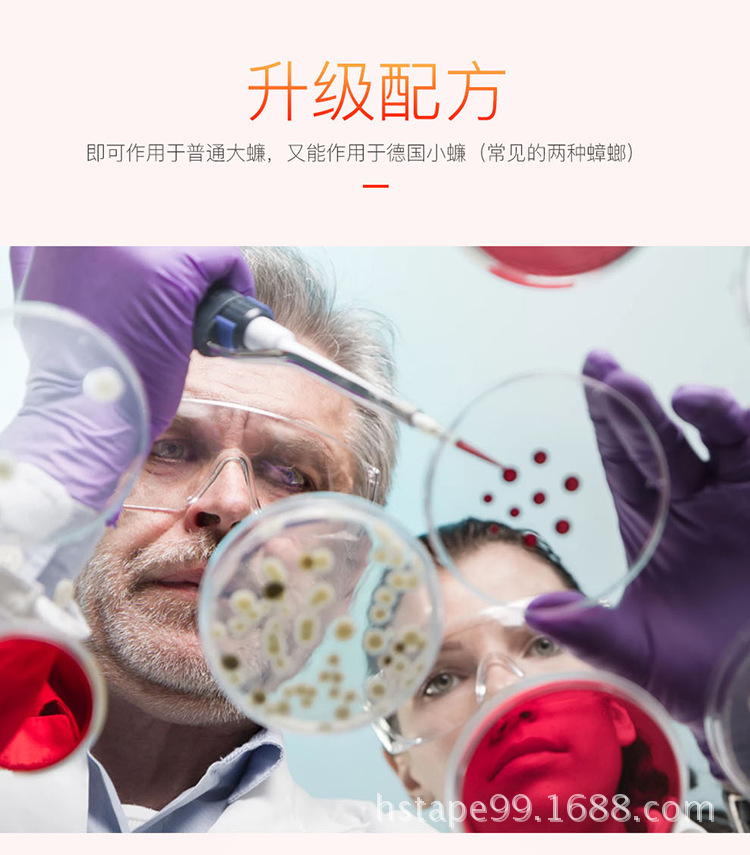
7.jpg

Search history
Clear allSearch by image
XDrag and drop an image here or upload an image
Max 5MB per image
UploadSign In | Join
X Email Mobile
| Number | Unit-price | Total | |||
| I want to buy: | × | 0.33 | = | 0 |
A new item has been added to your Shopping Cart. You now have items in your Shopping Cart.
Hensunyuan Tackiness Product Firm 14yr.
Contacts:陶宇翔Chat
Mobile:86-13750937106
E-mail:taoyushine@126.com
Packaging information
CTN Size: 44.5 × 39.5 × 21.5 cm
G.W./CTN:8.5 kg
QTY/CTN:1000 bag/carton

Update time:
TOP